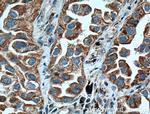
ARHGEF5 Antibody in Immunohistochemistry (Paraffin) (IHC (P))

Search
Proteintech
ARHGEF5 Polyclonal Antibody
{{$productOrderCtrl.translations['antibody.pdp.commerceCard.promotion.promotions']}}
{{$productOrderCtrl.translations['antibody.pdp.commerceCard.promotion.viewpromo']}}
{{$productOrderCtrl.translations['antibody.pdp.commerceCard.promotion.promocode']}}: {{promo.promoCode}} {{promo.promoTitle}} {{promo.promoDescription}}. {{$productOrderCtrl.translations['antibody.pdp.commerceCard.promotion.learnmore']}}

Please note: We are reviewing Western blot images included in the antibody testing data in our catalog, including those provided by third parties. Unless expressly labeled or annotated as “raw-unedited”, Western blot images included in the antibody testing data in our catalog may have been edited, optimized or otherwise adjusted for presentation.
产品信息
11379-1-AP
种属反应
已发表种属
宿主/亚型
分类
类型
抗原
偶联物
形式
浓度
规格
纯化类型
保存液
内含物
保存条件
运输条件
产品详细信息
Immunogen sequence: VCDVVLNHA PDFRRVYLPY VTNQTYQERT FQSLMNSNSN FREVLEKLES DPVCQRLSLK SFLILPFQRI TRLKLLLQNI LKRTQPGSSE EAEATKAHHA LEQLIRDCNN NVQSMRRTEE LIYLSQKIEF ECKIFPLISQ SRWLVKSGEL TALEFSASPG LRRKLNTRPV HLHLFNDCLL LSRPREGSRF LVFDHAPFSS IRGEKCEMKL HGPHKNLFRL FLRQNTQGAQ AEFLFRTETQ SEKLRWISAL AMPREELDLL ECYNSPQVQC LRAYKPREND ELALEKADVV MVTQQSSDGW LEGVRLSDGE RGWFPVQQVE FISNPEVRAQ NLKEAHRVKT AKLQLVEQQA (171-519 aa encoded by BC010046)
靶标信息
This gene encodes a protein that interacts with thyroid hormone receptors, also known as hormone-dependent transcription factors. The gene product interacts specifically with the ligand binding domain. This gene is one of several that may play a role in early-stage non-small cell lung cancer.
仅用于科研。不用于诊断过程。未经明确授权不得转售。
生物信息学
蛋白别名: ARH5; DKFZp686N1969; Ephexin 3; Rho guanine nucleotide exchange factor 5
基因别名: 2210412D05Rik; AA717842; Arhgef5; AW495314; Tim1
UniProt ID: (Mouse) E9Q7D5
Entrez Gene ID: (Mouse) 54324, (Rat) 140898




